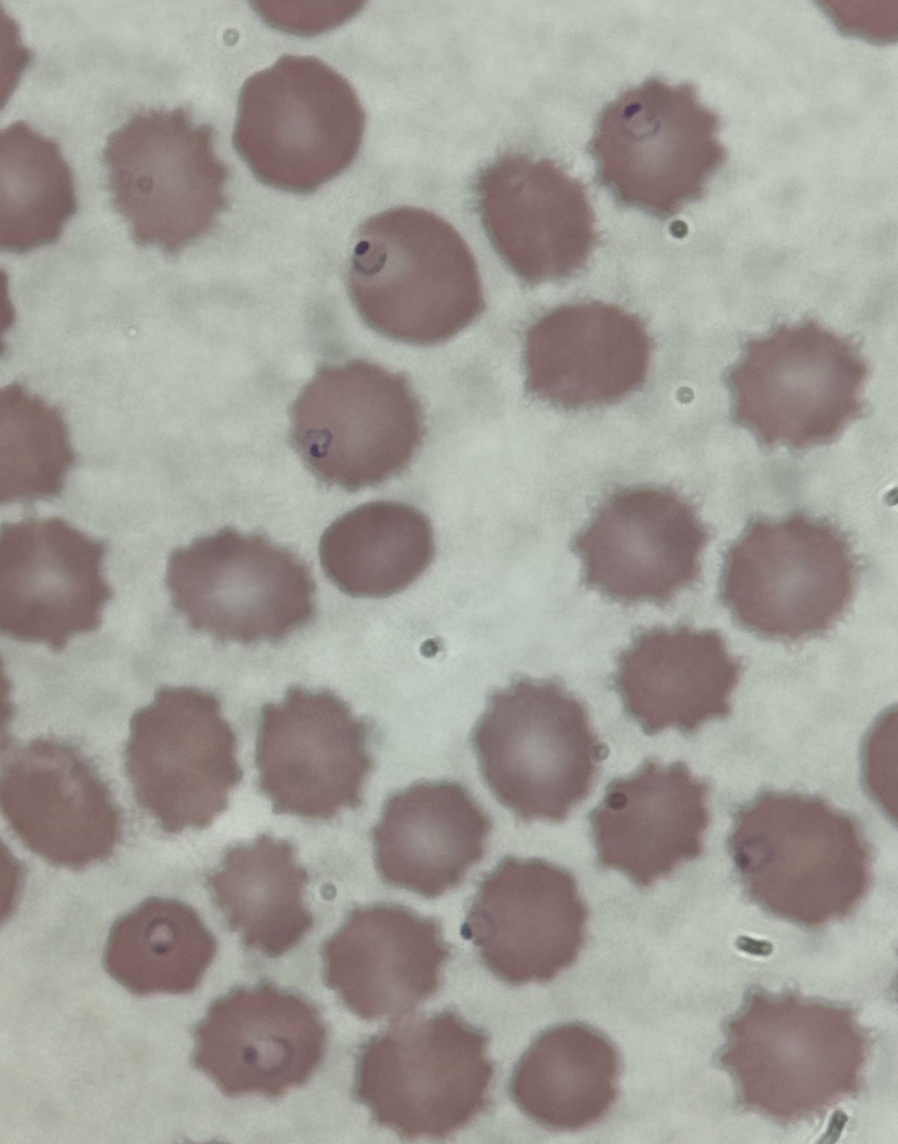

Case Presentation: 32-year-old male with history of Stevens Johnson’s syndrome secondary to sulfa allergy presented to the emergency department with vomiting, non-bloody diarrhea, chills and fatigue after returning from a 2-week trip to Africa. He was diagnosed with E coli gastroenteritis and discharged home. He returned four days later with on-going fevers, vomiting, diarrhea, body aches, and yellowing of the skin. On arrival, he was tachycardic to 130s, tachypneic in the 30s, and hypotensive requiring vasopressors. Pertinent labs included pancytopenia (WBC 3.1, hemoglobin 9.1 platelets of 7), renal impairment (Cr 3.4, BUN 65), and elevated lactate of 6.2. On exam, he was awake and alert, tender over the lower abdomen, with diffuse anasarca. Peripheral blood smear confirmed Plasmodium falciparum (Figure 1), initial parasitemia of 11% that quickly doubled to 22%. He was transferred to a higher-level care center to receive IV Artesunate therapy 175 mg every 12 hours. He clinically improved with supportive care and the first two doses of artesunate; oliguric renal failure also normalized. He received four total doses of IV Artesunate, then transitioned to oral therapy with Artemether-lumefantrine (Coartem) after significant reduction in parasitemia (Figure 2). Patient’s pancytopenia improved with a hemoglobin on discharge of 8.3 and platelet count 96. Patient re-admitted 5 days later with hemoglobin 6.4, LDH 2,192, total bilirubin 3.8, reticulocyte 4.3%; patient endorsed dark urine. He received 3 units packed RBCs and was started on a prednisone taper. Repeat parasitology revealed no organisms on thin or thick smear. After symptomatic improvement and stabilization of hemoglobin with steroid therapy, the patient was discharged with plans to follow up with hematology-oncology.
Discussion: In non-falciparum malaria, parasitemia rarely exceeds 2%, whereas it can be considerable higher (>50%) in falciparum malaria. Severe malaria infections are characterized by shock, acute renal failure, respiratory distress, and can lead to seizures and coma. Hyperparasitemia (> 500,000 parasites/mm3) is associated with a poorer prognosis. On admission, the patient was started on empiric broad-spectrum antibiotics for shock with an elevated procalcitonin and C-reactive protein. These antibiotics were discontinued due to concern for hemolytic uremic syndrome (HUS) in the setting of E. coli diarrheal illness, as the resultant hemolysis from HUS can appear similar to malaria. Despite completion of anti-malarial therapy and resolution in parasitemia, the patient continued to have hemolysis, and required multiple transfusions for stabilization. On-going hemolytic anemia may be attributed to a delayed reaction to the antimalarial medication, a condition called post-artesunate delayed hemolysis (PADH) in which RBCs carrying dead parasites are cleared by the spleen. These RBCs, however, have a shortened lifespan of 7-21 days and patients present with clinical features of anemia one week after initiation of artesunate.
Conclusions: This case demonstrated the severity with which falciparum malaria can devastate the body, with life-threatening hemolytic anemia continuing after eradication of the organism. Further workup will be required to determine if the on-going anemia is delayed hemolysis after malaria infection versus adverse effect from the antimalarial. Nevertheless, it is likely that without Artesunate therapy, the patient’s infection would have progressed further and possibly been fatal.